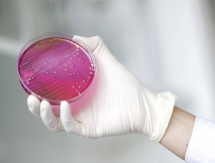

Новости казахстанского спорта за 20 октября 2025 года
20 октября, 2025
В новостях
-
 Бокс/ММАИэн Гэрри отказал Белалу Мухаммаду
Бокс/ММАИэн Гэрри отказал Белалу Мухаммаду -
 Бокс/ММАКайрат Сатжанов выбрал кандидатов в сборную Казахстана
Бокс/ММАКайрат Сатжанов выбрал кандидатов в сборную Казахстана -
 LifestyleНадо ли менять дворники автомобиля на зимние
LifestyleНадо ли менять дворники автомобиля на зимние -
 ЗдоровьеНайден способ защитить легкие от опасного рубцевания
ЗдоровьеНайден способ защитить легкие от опасного рубцевания -
 Хоккей«Снежные Барсы» проиграли «Капитану» в матче МХЛ
Хоккей«Снежные Барсы» проиграли «Капитану» в матче МХЛ -
 LifestyleБольшинство даже не догадывается — что означают наклейки с цифрами на яблоках
LifestyleБольшинство даже не догадывается — что означают наклейки с цифрами на яблоках -
 ФутболОзвучены три сценария Узбекистана на ЧМ-2026 по футболу
ФутболОзвучены три сценария Узбекистана на ЧМ-2026 по футболу -
 ЗдоровьеКакая бактерия помогает раку скрываться от иммунной системы
ЗдоровьеКакая бактерия помогает раку скрываться от иммунной системы -
 Бокс/ММАТоповый боец UFC намекнул на бой с Илией Топурией
Бокс/ММАТоповый боец UFC намекнул на бой с Илией Топурией -
 Футбол«Астане» и «Актобе» указали на проблему после матча в КПЛ
Футбол«Астане» и «Актобе» указали на проблему после матча в КПЛ
Ещё новости
Идёт загрузка...
В статьях
-
 Футбол«Встречаются два аутсайдера, у которых шансов на выход нет». Вячеслав Эрбес разобрал матча с «Пафосом» и перспективы «Кайрата» в Лиге Чемпионов1
Футбол«Встречаются два аутсайдера, у которых шансов на выход нет». Вячеслав Эрбес разобрал матча с «Пафосом» и перспективы «Кайрата» в Лиге Чемпионов1 -
 ФутболДебютанты Лиги Чемпионов встретятся в Алматы. Удастся ли кому-то из них наконец победить?
ФутболДебютанты Лиги Чемпионов встретятся в Алматы. Удастся ли кому-то из них наконец победить? -
 Футбол«Победы „Кайрата“ и „Астаны“ закономерны». Булат Есмагамбетов разобрал матчи 25-го КПЛ-2025
Футбол«Победы „Кайрата“ и „Астаны“ закономерны». Булат Есмагамбетов разобрал матчи 25-го КПЛ-2025 -
 Футбол«Почему вы вообще переживаете? В Казахстане не знают, как играть в футбол». Что пишут фанаты «Пафоса» перед матчем с «Кайратом»5
Футбол«Почему вы вообще переживаете? В Казахстане не знают, как играть в футбол». Что пишут фанаты «Пафоса» перед матчем с «Кайратом»5 -
 ФутболРоберто Карлос попробовал национальную кухню Казахстана2
ФутболРоберто Карлос попробовал национальную кухню Казахстана2 -
 Футбол«Наилучший шанс войти в историю». Кипрские СМИ ждут от «Пафоса» победу любой ценой в Алматы2
Футбол«Наилучший шанс войти в историю». Кипрские СМИ ждут от «Пафоса» победу любой ценой в Алматы2
В фото
-
Бокс/ММАХамзату Чимаеву сделали необычный подарок
-
ВолейболСабина Алтынбекова восхитила фанатов в образе степной царицы. Фото1
В видео
-
Бокс/ММАНокаутом завершился бой за два титула в весе Жанибека Алимханулы. Видео
-
Бокс/ММАНазым Кызайбай оседлала коня в турецком фильме. Видео
-
Бокс/ММАЧарльз Оливейра стал необычным чемпионом. Видео
Ещё видео
Идёт загрузка...